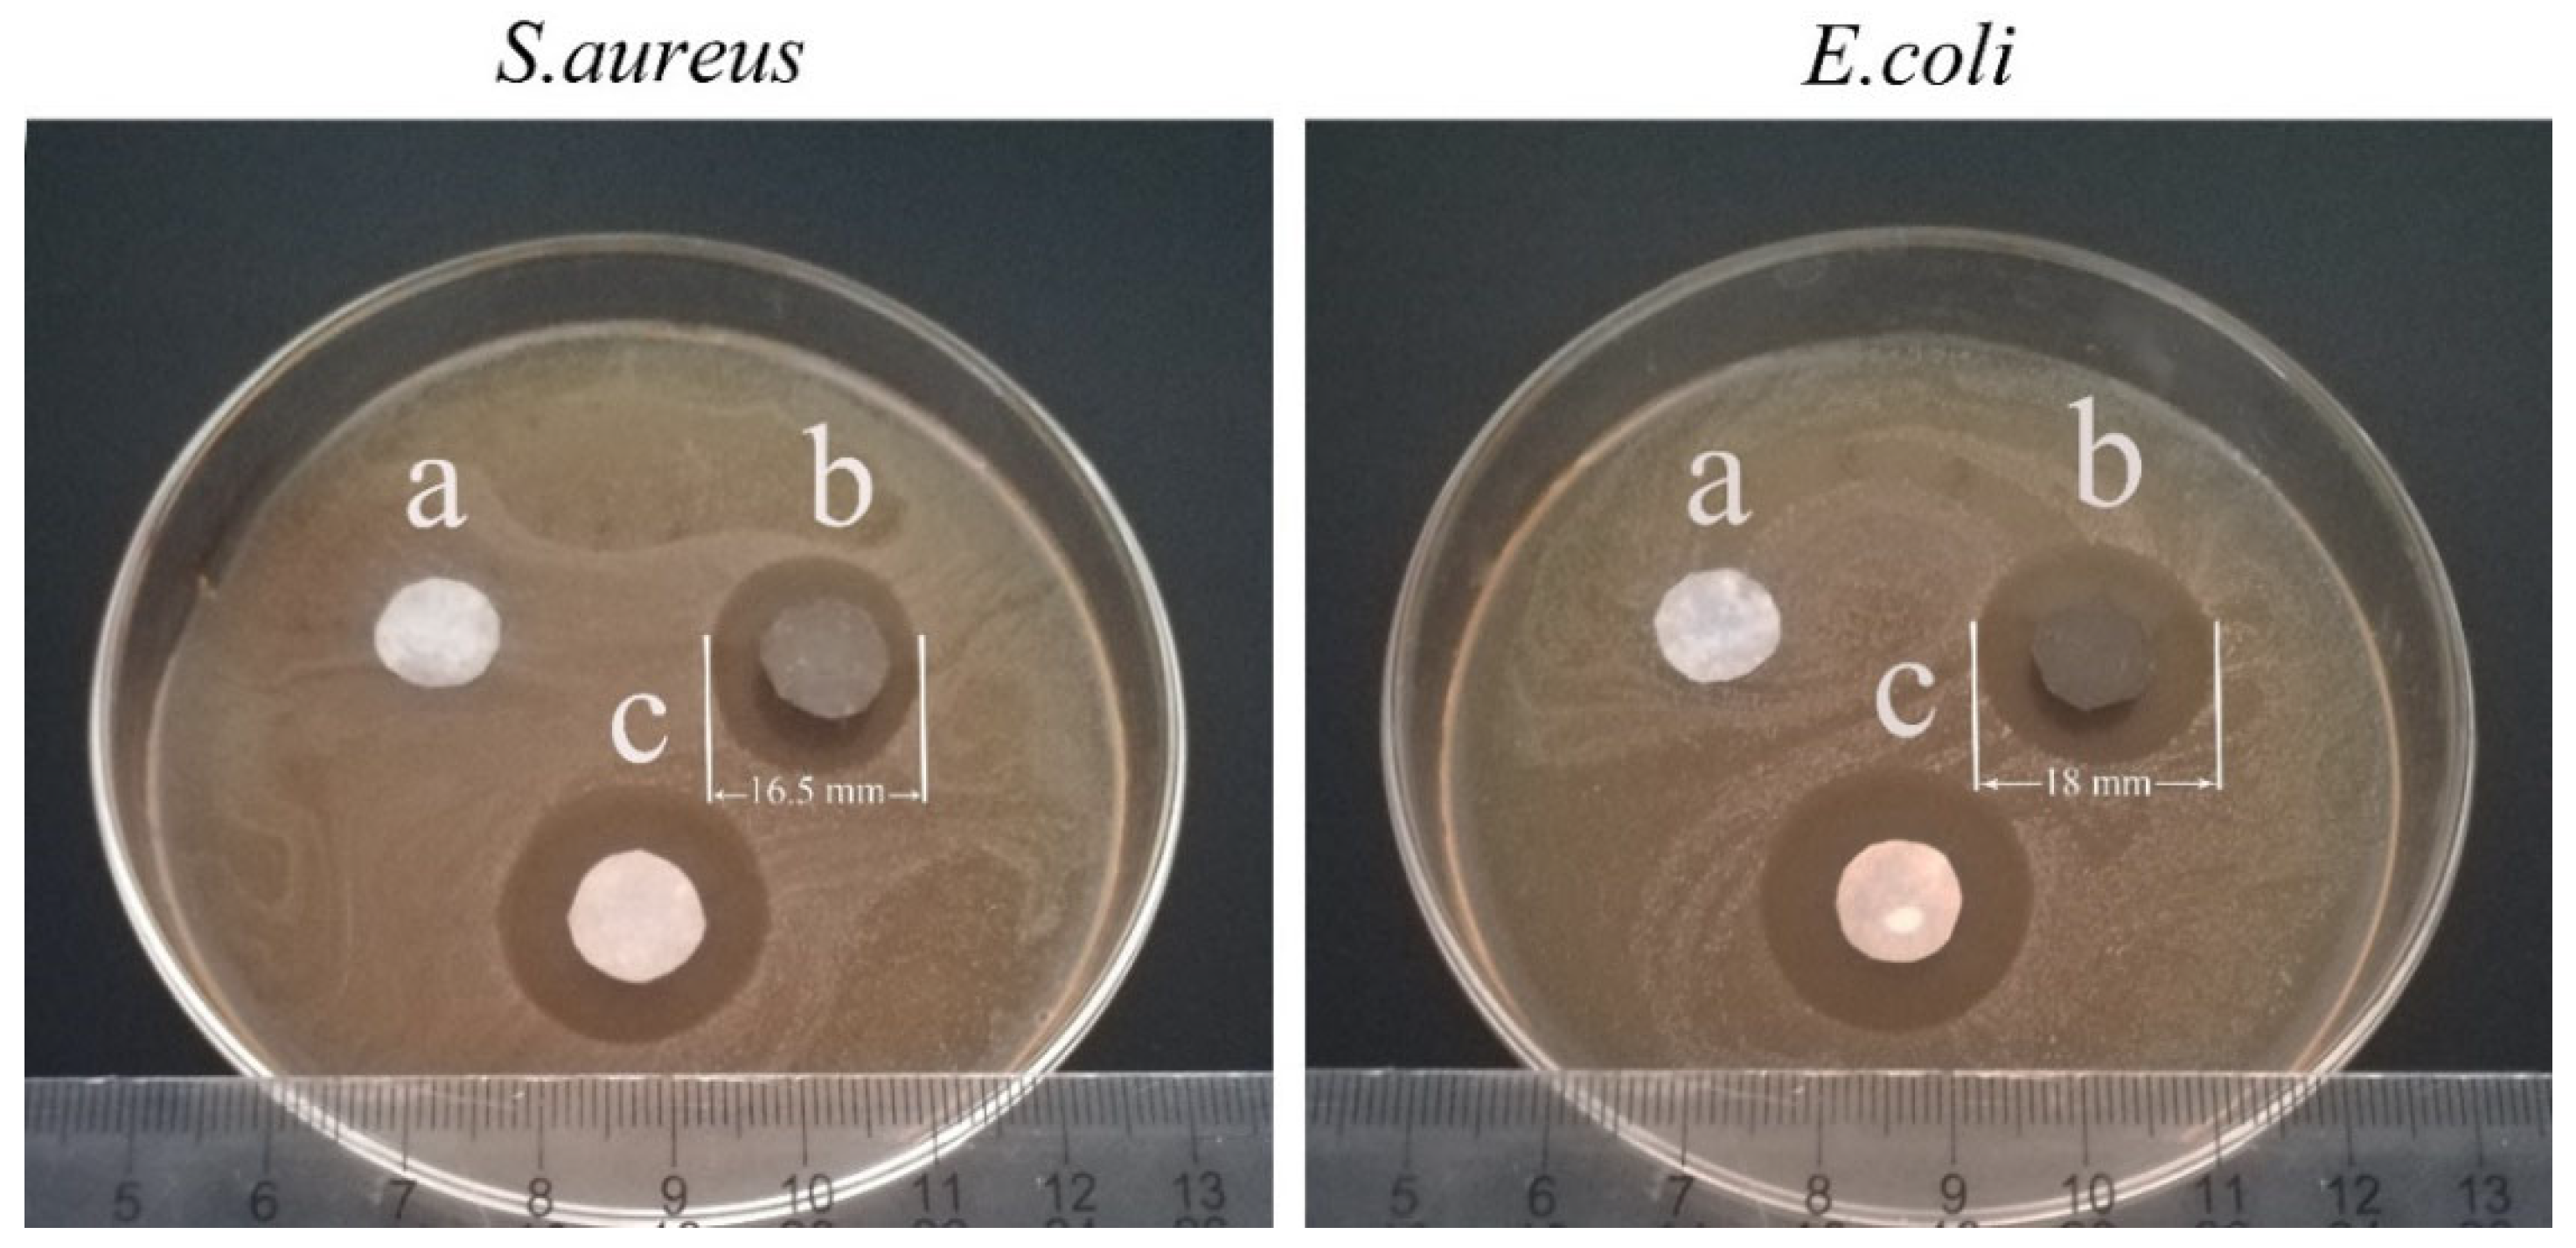
Processes 10 00961 g008 550

Flexible, Strong and Multifunctional Anf@Ag Nanocomposite Film for Human Physiology and Motion Monitoring
Abstract
:1. Introduction
2. Experimental
2.1. Materials
2.2. Preparation of the Ag NPs
2.3. Preparation of the ANF Dispersion
2.4. Preparation of the ANF@Ag Nanocomposite Film
2.5. Characterization and Measurement
3. Results and Discussion
3.1. Preparation and Microstructure
3.2. Physical Properties
3.3. Electrical Conductivity, Surface Wettability and Antibacterial Properties
3.4. Sensing Performance
4. Conclusions
Supplementary Materials
Author Contributions
Funding
Informed Consent Statement
Conflicts of Interest
References
- Hao, B.; Mu, L. Stretchable and compressible strain sensor based on carbon nanotube foam/polymer nanocomposites with three-dimensional networks. Compos. Sci. Technol. 2018, 163, 162–170. [Google Scholar] [CrossRef]
- Luo, S.; Zhou, X. Nano energy microconformal electrode-dielectric integration for flexible ultrasensitive robotic tactile sensing. Nano Energy 2020, 80, 105580. [Google Scholar] [CrossRef]
- Tien, N.T.; Jeon, S. A flexible bimodal sensor array for simultaneous sensing of pressure and temperature. Adv. Mater. 2013, 26, 796–804. [Google Scholar] [CrossRef] [PubMed]
- Honda, W.; Harada, S. High-performance, mechanically flexible, and vertically integrated 3D carbon nanotube and In GaZnO complementary circuits with a temperature sensor. Adv. Mater. 2015, 27, 4674–4680. [Google Scholar] [CrossRef]
- Dinh, T.; Phan, H.P. Environment-friendly carbon nanotube based flexible electronics for noninvasive and wearable healthcare. J. Mater. Chem. C 2016, 4, 10061–10068. [Google Scholar] [CrossRef]
- Shin, J.; Jeong, B. Sensitive wearable temperature sensor with seamless monolithic integration. Adv. Mater. 2019, 32, 1905527. [Google Scholar] [CrossRef]
- Bai, W.; Yang, H. Flexible transient optical waveguides and surface-wave biosensors constructed from monocrystalline silicon. Adv. Mater. 2018, 30, 1801584. [Google Scholar] [CrossRef]
- Dong, Y.; Akinoglu, E.M. An optically responsive soft etalon based on ultrathin cellulose hydrogels. Adv. Funct. Mater. 2019, 29, 1904290. [Google Scholar] [CrossRef]
- Reda, A.; El-safty, S.A. Biosensors and bioelectronics optical glucose biosensor built-in disposable strips and wearable electronic devices. Biosens. Bioelectron. 2021, 185, 1132–1137. [Google Scholar] [CrossRef]
- Liu, K.; Sakurai, M. Enhancing the humidity sensitivity of Ga2O3/SnO2 core/shell microribbon by applying mechanical strain and its application as a flexible strain sensor. Small 2012, 8, 3599–3604. [Google Scholar] [CrossRef]
- Feng, Y.; Gong, S. TaS2 nanosheet-based ultrafast response and flexible humidity sensor for multifunctional applications. J. Mater. Chem. C 2019, 7, 9284–9292. [Google Scholar] [CrossRef]
- Zhang, D.; Xu, Z. High-performance flexible self-powered tin disulfide nanoflowers/reduced graphene oxide nanohybrid-based humidity sensor driven by triboelectric nanogenerator. Nano Energy 2019, 67, 1042–1051. [Google Scholar] [CrossRef]
- Alluri, N.R.; Selvarajan, S. Piezoelectric BaTiO3/alginate spherical composite beads for energy harvesting and self-powered wearable flexion sensor. Compos. Sci. Technol. 2017, 142, 65–78. [Google Scholar] [CrossRef]
- Wang, J.; Jiang, J. Energy-efficient, fully flexible, high-performance tactile sensor based on piezotronic effect: Piezoelectric signal amplified with organic field-effect transistors. Nano Energy 2020, 76, 105050. [Google Scholar] [CrossRef]
- Zhou, H.; Wang, Z. Robust and sensitive pressure/strain sensors from solution processable composite hydrogels enhanced by hollow-structured conducting polymers. Chem. Eng. J. 2020, 403, 126307. [Google Scholar] [CrossRef]
- Li, R.; Si, Y. Supercapacitive iontronic nanofabric sensing. Adv. Mater. 2017, 29, 1700253. [Google Scholar] [CrossRef]
- Narongthong, J.; Das, A. An efficient highly flexible strain sensor: Enhanced electrical conductivity, piezoresistivity and flexibility of a strongly piezoresistive composite based on conductive carbon black and an ionic liquid. Compos. Part A Appl. Sci. Manuf. 2018, 113, 330–338. [Google Scholar] [CrossRef]
- Dong, X.; Wei, Y. A linear and large-range pressure sensor based on a graphene/silver nanowires nanobiocomposites network and a hierarchical structural sponge. Compos. Sci. Technol. 2017, 155, 108–116. [Google Scholar] [CrossRef]
- Cheng, L.; Qian, W. A highly sensitive piezoresistive sensor with interlocked graphene microarrays for meticulous monitoring of human motions. J. Mater. Chem. C. 2020, 8, 11525–11531. [Google Scholar] [CrossRef]
- Chang, K.; Li, L. Compressible and robust PANI sponge anchored with erected MXene flakes for human motion detection. Compos. Part A Appl. Sci. Manuf. 2021, 151, 106671. [Google Scholar] [CrossRef]
- Zheng, S.; Wu, X. Highly sensitive and multifunctional piezoresistive sensor based on polyaniline foam for wearable human-activity monitoring. Compos. Part A Appl. Sci. Manuf. 2019, 121, 510–516. [Google Scholar] [CrossRef]
- Zheng, S.; Jiang, Y. Highly sensitive pressure sensor with broad linearity via constructing a hollow structure in polyaniline/polydimethylsiloxane composite. Compos. Sci. Technol. 2020, 201, 108546. [Google Scholar] [CrossRef]
- Zhong, M.; Zhang, L. Wide linear range and highly sensitive flexible pressure sensor based on multistage sensing process for health monitoring and human-machine interfaces. Chem. Eng. J. 2021, 412, 128649. [Google Scholar] [CrossRef]
- Wang, Z.; Bi, P. Star-nose-inspired multi-mode sensor for anisotropic motion monitoring. Nano Energy 2020, 80, 105559. [Google Scholar] [CrossRef]
- Mariello, M.; Qualtieri, A. Metal-free multilayer hybrid PENG based on soft electrospun/-sprayed membranes with cardanol additive for harvesting energy from surgical face masks. ACS Appl. Mater. Interfaces 2021, 13, 20606–20621. [Google Scholar] [CrossRef]
- Park, B.; Lee, W. Highly tunable interfacial adhesion of glass fiber by hybrid multilayers of graphene oxide and aramid nanofiber. ACS Appl. Mater. Interfaces 2015, 7, 3329–3334. [Google Scholar] [CrossRef]
- Lyu, J.; Wang, X. High strength conductive composites with plasmonic nanoparticles aligned on aramid nanofibers. Adv. Funct. Mater. 2016, 26, 8435–8445. [Google Scholar] [CrossRef]
- Kwon, S.R.; Elinski, M.B. Robust and flexible aramid nanofiber/graphene layer-by-layer electrodes. ACS Appl. Mater. Interfaces 2017, 9, 17125–17136. [Google Scholar] [CrossRef]
- Wang, L.; Zhang, M. Highly compressible, thermally stable, light- weight, and robust aramid nanofibers/Ti3AlC2 MXene composite aerogel for sensitive pressure sensor. ACS Nano 2020, 14, 10633–10647. [Google Scholar] [CrossRef] [PubMed]
- Tang, Y.; Guo, Q. In-situ reduction of graphene oxide-wrapped porous polyurethane sca ff olds: Synergistic enhancement of mechanical properties and piezoresistivity. Compos. Part A Appl. Sci. Manuf. 2018, 116, 106–113. [Google Scholar] [CrossRef]
- Kim, K.; Jung, M. Low-voltage, high-sensitivity and high-reliability bimodal sensor array with fully inkjet-printed flexible conducting electrode for low power consumption electronic skin. Nano Energy. 2017, 41, 301–307. [Google Scholar] [CrossRef]
- Chang, Y.; Wang, L. First decade of interfacial iontronic sensing: From droplet sensors to artificial skins. Adv. Mater. 2020, 33, 2003464. [Google Scholar] [CrossRef] [PubMed]
- Ma, T.; Zhao, Y. Highly thermal conductivities, excellent mechanical robustness and flexibility, and outstanding thermal stabilities of aramid nanofiber composite papers with nacre-mimetic layered structures. ACS Appl. Mater. Interfaces 2020, 12, 1677–1686. [Google Scholar] [CrossRef] [PubMed]
- Xiong, Y.; Shen, Y. A flexible, ultra-highly sensitive and stable capacitive pressure sensor with convex microarrays for motion and health monitoring. Nano Energy 2019, 70, 104436. [Google Scholar] [CrossRef]
- Yang, J.; Mun, J. Electronic skin: Recent progress and future prospects for skin-attachable devices for health monitoring, robotics, and prosthetics. Adv. Mater. 2019, 31, 1904765. [Google Scholar] [CrossRef] [PubMed] [Green Version]
- Wu, Q.; Qiao, Y. Triode-mimicking graphene pressure sensor with positive resistance variation for physiology and motion monitoring. ACS Nano 2020, 14, 10104–10114. [Google Scholar] [CrossRef]
- Li, Z.; Zhang, B. A wide linearity range and high sensitivity flexible pressure sensor with hierarchical microstructures via laser marking. J. Mater. Chem. C 2020, 8, 3088–3096. [Google Scholar] [CrossRef]
- Shu, Q.; Hu, T. Non-tensile piezoresistive sensor based on coaxial fiber with magnetoactive shell and conductive flax core. Compos. Part A Appl. Sci. Manuf. 2021, 149, 106548. [Google Scholar] [CrossRef]
- Yang, M.; Cao, K.Q. Dispersions of aramid nanofibers: A new nanoscale building block. ACS Nano 2014, 5, 6945–6954. [Google Scholar] [CrossRef] [Green Version]
- Wang, F.; Wu, Y. Strong, transparent and flexible aramid nanofiber/POSS hybrid organic/inorganic nanocomposite membranes. Compos. Sci. Technol. 2018, 156, 269–275. [Google Scholar] [CrossRef]
- Upadhyay, J.; Kumar, A. Investigation of structural, thermal and dielectric properties of polypyrrole nanotubes tailoring with silver nanoparticles. Compos. Sci. Technol. 2014, 97, 55–62. [Google Scholar] [CrossRef]
- Zeng, F.; Chen, X. A bioinspired ultratough multifunctional mica-based nanopaper with 3D aramid nanofiber framework as an electrical insulating material. ACS Nano 2020, 14, 611–619. [Google Scholar] [CrossRef] [PubMed]
- Wang, L.; Li, H. Monodisperse, micrometer-scale, highly crystalline, nanotextured Ag dendrites: Rapid, large-scale, wet-chemical synthesis and their application as SERS substrates. ACS Appl. Mater. Interfaces 2010, 2, 2987–2991. [Google Scholar] [CrossRef] [PubMed]
- Gao, X.; Esteves, R.J.A. Direct cross-linking of Au/Ag alloy nanoparticles into monolithic aerogels for application in surface-enhanced raman scattering. ACS Appl. Mater. Interfaces 2016, 8, 13076–13085. [Google Scholar] [CrossRef] [PubMed]
- Liu, Y.; Gu, H. Design and preparation of biomimetic polydimethylsiloxane (PDMS) films with superhydrophobic, self-healing and drag reduction properties via replication of shark skin and SI-ATRP. Chem. Eng. J. 2018, 356, 318–328. [Google Scholar] [CrossRef]
- Chang, Y.; Cheng, Y. Upshift of the d band center toward the Fermi level for promoting silver ion release, bacteria inactivation, and wound healing of alloy silver nanoparticles. ACS Appl. Mater. Interfaces 2019, 11, 12224–12231. [Google Scholar] [CrossRef]
- You, I.; Choi, S.E. E-skin tactile sensor matrix pixelated by position-registered conductive microparticles creating pressure-sensitive selectors. Adv. Funct. Mater. 2018, 28, 1–10. [Google Scholar] [CrossRef]

Publisher’s Note: MDPI stays neutral with regard to jurisdictional claims in published maps and institutional affiliations. |
© 2022 by the authors. Licensee MDPI, Basel, Switzerland. This article is an open access article distributed under the terms and conditions of the Creative Commons Attribution (CC BY) license (https://creativecommons.org/licenses/by/4.0/).
Share and Cite
Long, H.; Li, Q.; Peng, S.; Chen, S.; Zhang, T.; Zhang, M.; Li, M.; Chen, L. Flexible, Strong and Multifunctional Anf@Ag Nanocomposite Film for Human Physiology and Motion Monitoring. Processes 2022, 10, 961. https://doi.org/10.3390/pr10050961
Long H, Li Q, Peng S, Chen S, Zhang T, Zhang M, Li M, Chen L. Flexible, Strong and Multifunctional Anf@Ag Nanocomposite Film for Human Physiology and Motion Monitoring. Processes. 2022; 10(5):961. https://doi.org/10.3390/pr10050961
Chicago/Turabian StyleLong, Haofan, Qing Li, Shulan Peng, Shiqiang Chen, Tonghua Zhang, Mingyuan Zhang, Minghua Li, and Lei Chen. 2022. "Flexible, Strong and Multifunctional Anf@Ag Nanocomposite Film for Human Physiology and Motion Monitoring" Processes 10, no. 5: 961. https://doi.org/10.3390/pr10050961
APA StyleLong, H., Li, Q., Peng, S., Chen, S., Zhang, T., Zhang, M., Li, M., & Chen, L. (2022). Flexible, Strong and Multifunctional Anf@Ag Nanocomposite Film for Human Physiology and Motion Monitoring. Processes, 10(5), 961. https://doi.org/10.3390/pr10050961





